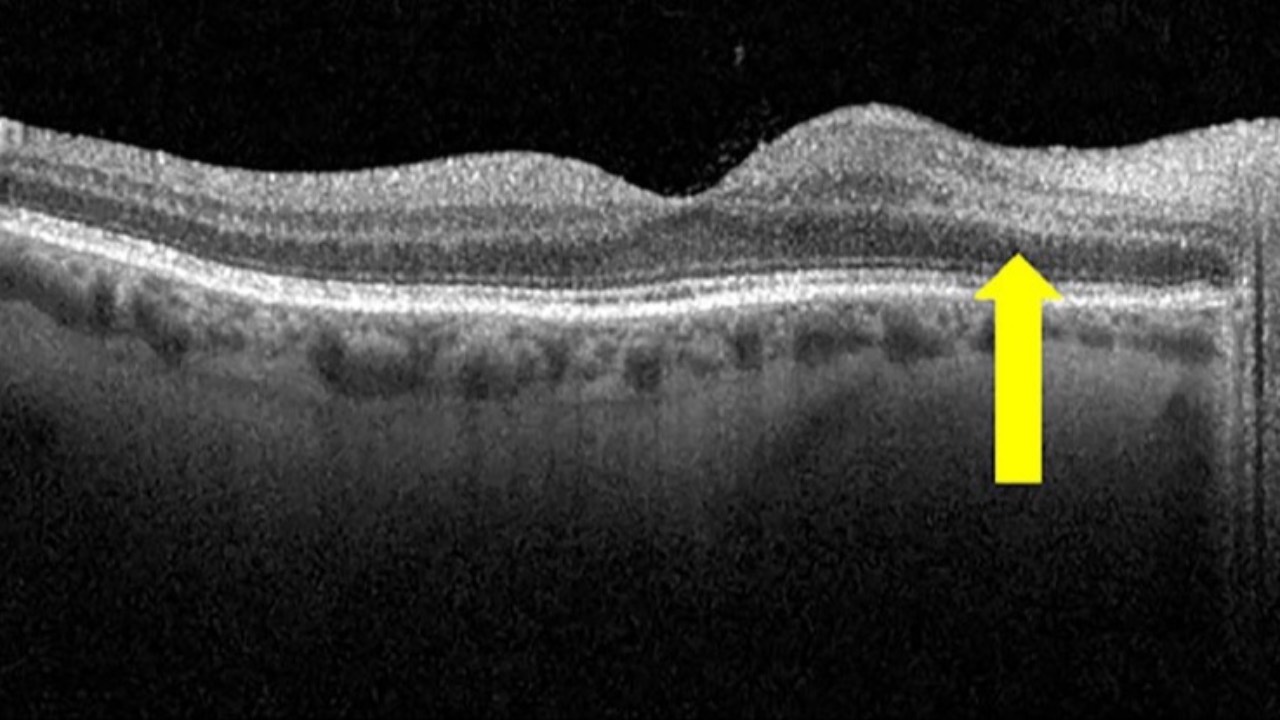

OCT Biomarkers: NAION vs AAION
Do you know what to look for?...
Paracentral acute middle maculopathy (PAMM) and retinal fluid may serve as high-yield biomarkers in distinguishing between arteritic anterior ischemic optic neuropathy (AAION) and non-arteritic anterior ischemic optic neuropathy (NAION). It appears the presence of...
by John R Martinelli MD OD FAAO —
Feb 18, 2025
Narrow Angles: Decisions. Decisions.
Peripheral Iridotomy (LPI)...should you or shouldn't you?
A systematic review and meta-analysis just published looked at the progression of primary angle closure suspects (PACS) to more advanced stages of angle closure.
The results from 1,997 PACS patients with an average follow-up of 6.2 years,...
by John R Martinelli MD OD FAAO —
Feb 13, 2025
Central Serous Chorioretinopathy Redux
Sometimes personality really doesn't matter...
Central Serous Chorioretinopathy (CSC) has long been associated with younger stressed-out males & Type A personalities - likely due to higher circulating cortisol levels being released via the adrenals. Exogenous corticosteroid use has also been a m...
by John R Martinelli MD OD FAAO —
Feb 11, 2025
OCT Before Cataract Surgery
Yes or No?...
Optical coherence tomography (OCT) can be a valuable tool screening for hidden maculopathy prior to cataract surgery, offering us high-yield findings beyond traditional retinal exams and color photos.
It was recently shown around 21.5% of eyes cleared for cataract surgery with norm...
by John R Martinelli MD OD FAAO —
Feb 06, 2025
Glaucoma & BP: Focal Ischemic vs Cupping
Do you watch the notch?...
There appears to be differential effects of blood pressure on progression rates in focal ischemic versus generalized cup enlargement in glaucomatous optic neuropathy.
Focal ischemic glaucomatous optic neuropathy characterized by localized optic nerve damage, aka "notch...
by John R Martinelli MD OD FAAO —
Feb 04, 2025
Atrial Fibrillation & Glaucoma
What do you tell your patients?...
A recent case control study looking at rates of glaucomatous visual field progression before and after the onset of atrial fibrillation found important outcomes for us to consider.
Longitudinal results and meta-analyses found a significant change in visual fiel...
by John R Martinelli MD OD FAAO —
Jan 30, 2025
Astigmatism: FEMTO vs TORIC IOLs
Why do you choose what you choose?...
A randomized clinical trial published this week compared the efficacy of femtosecond laser arcuate keratotomy (FLAK) versus toric intraocular lenses (IOL) in cataract surgery patients with corneal astigmatism.
Important outcomes were looked at, including vis...
by John R Martinelli MD OD FAAO —
Jan 28, 2025
Stroke Risk & Retinal Vasculature
Do you know what to look for?...
Findings published this week uncovered a significant association between retinal vascular geometry and silent brain infarction (SBI), possibly offering us new clues in terms of stroke risk.
227 SBI patients and matched controls were studied which showed lower fra...
by John R Martinelli MD OD FAAO —
Jan 24, 2025
Kinky Normal Tension Glaucoma
Yes, you read that right...
There appears to be a significantly higher incidence of optic nerve kinking in individuals with normal tension glaucoma (NTG) compared to healthy controls. This finding was discovered after retro-bulbar/orbital optic nerve imaging utilizing CT cisternography and MRI in...
by John R Martinelli MD OD FAAO —
Jan 21, 2025
Circadian Rhythm Of The Cornea
Does it exist and does it matter?
A small study has uncovered surprising insights into corneal chronobiology, challenging long-held assumptions about overnight corneal changes. Results with 64 participants across a wide age range (21-76 years) revealed corneal thickness increases during nocturnal...
by John R Martinelli MD OD FAAO —
Jan 17, 2025
Snoring & Keratoconus
Is there really a connection?
A bidirectional Mendelian randomization study has found interesting evidence supporting the role of snoring in keratoconus (KCN). This was uncovered utilizing genetic variations with analyzed data from over 400,000 participants.
The results revealed a causal effect ...
by John R Martinelli MD OD FAAO —
Jan 14, 2025
Fuchs Corneal Dystrophy & Ready For Surgery
Your patient asks you what's best. What do you say?...
Ten-year outcomes in corneal transplantation techniques have yielded important insights to help us advise individuals with Fuchs endothelial corneal dystrophy who are considering surgery. Surprisingly, penetrating keratoplasty (PK) demonstra...
by John R Martinelli MD OD FAAO —
Jan 10, 2025
 MedEye Minute Newsletter
MedEye Minute Newsletter